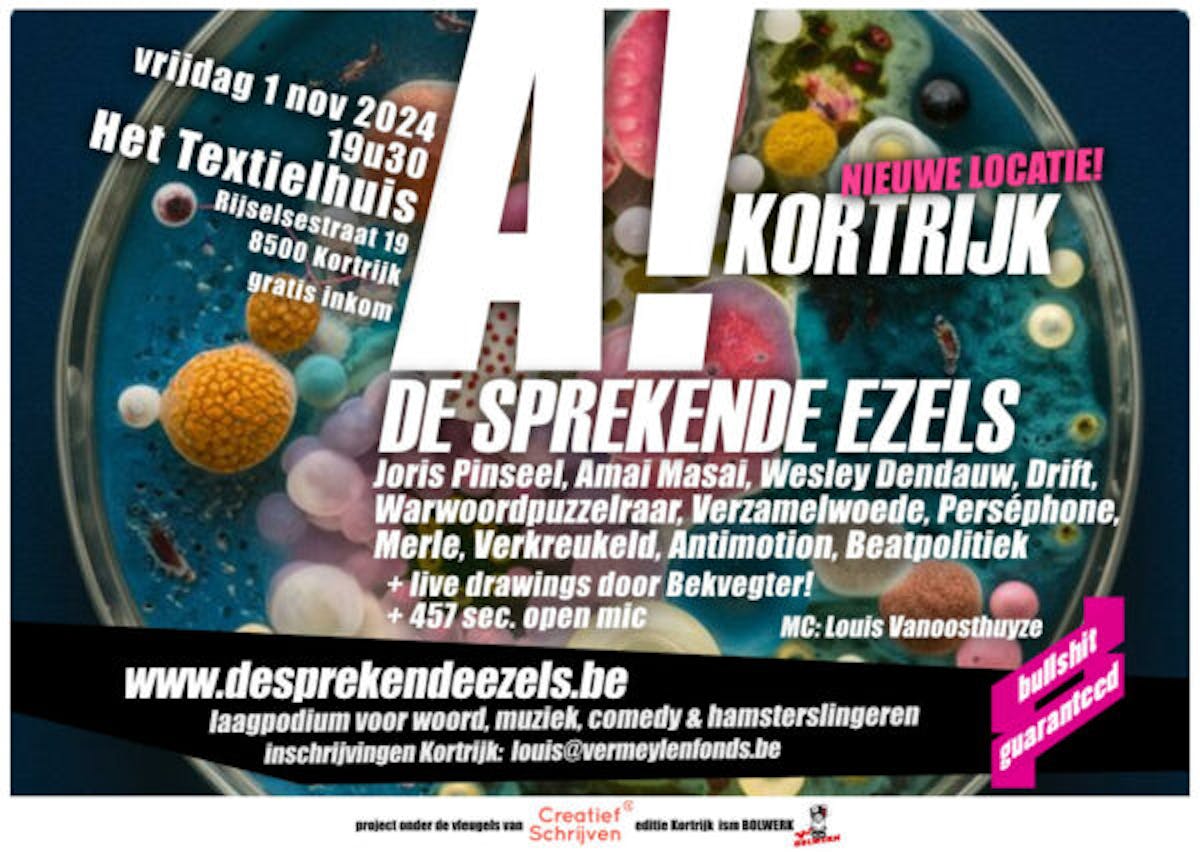

De Sprekende Ezels Kortrijk
De Sprekende Ezels is ons laagpodium voor woord, muziek, comedy, hamerslingeren, enz.
Je ontdekt er kersvers en gevestigd talent. Van harte welkom!
Ook om zelf eens op het podium te klimmen.
Op het podium in Kortrijk: Joris Pinseel, Amai Masai, Wesley Dendauw, Drift, Warwoordpuzzelraar, Veramelwoede, Perséphone, Merle, Verkreukeld, Antimotion, Beatpolitiek
+live drawings door Bekvegter
+457 sec open mic
MC: Louis Vanoosthuyze
Op de website van De Sprekende Ezels ontdek je meer info en kan je ook zelf een plaats op één van de podia reserveren. Niet twijfelen, gewoon doen! We zijn benieuwd naar jouw verhaal.